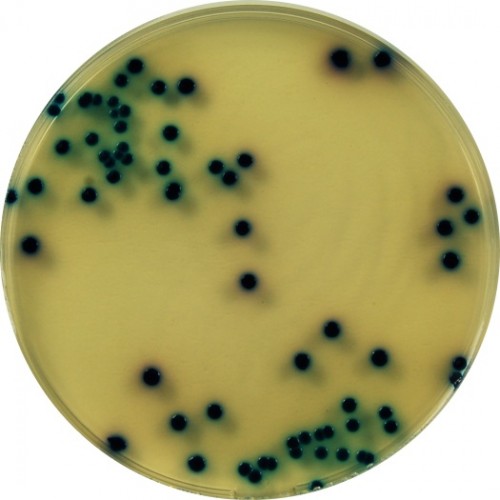

חדשות מהינשוף גיליון 83
החזרה יזומה של מוצרים ברחבי העולם
Arcadie Sud Ouest Produits Elabores E. coli O102:H2 RRG Urtekran International Vita Foods ApS Clover Farms יצרן: Saveurs De Rhuys מותג: Saloir Josselin Listeria monocytogenes Les Vergers Du Patrimoine SuperValu Phoenix Caraman Fruit Marine Harvest Listeria monocytogenes Angry Orchard Safeway Vibrio parahaemolyticus Jealsa Chetak New York Smirnoff Ice Kraft Heinz Asda Fornaio Village Brewery מדובר בבקבוקים אשר אוחסנו שלא בהתאם לדרישות המוצר. זוהי הפעם השנייה שהחברה מתמודדת עם הבעיה, לאחר שבשנה שעברה יצאה בהודעה דומה NatPets רצועות בקר לכלבים: I and love and You Carrefour
מדינה
שם חברה
מוצר
גורם סיכון
פגיעה בצרכנים
הערות
מידע נוסף
צרפת
המבורגר בקר לא מוכן לאכילה
לא ידוע
קישור
צרפת
יין
שבר בזמן פתיחת הבקבוק
לא ידוע
קישור
דנמרק
צימוקים אורגניים
אוכראטוקסין A
לא ידוע
קישור
דנמרק
קמח דורום
הימצאות זחלי חרקים בחלק מהמוצרים
לא ידוע
קישור
ארה"ב
חלב שתיה במכלי פלסטיק
הימצאות חלקי פלסטיק בתוך המכלים
לא ידוע
קישור
צרפת
מוצרי נקניק מעושן
לא ידוע
קישור
הרפובליקה הרוסית- טטרסטן
פומידורקה - Agro Invest
שימורי עגבניות
בוטולינום טוקסין
ידוע על מקרה תחלואה בודד
קישור
צרפת
סיידר בבקבוק
הימצאות חלקי זכוכית באריזת המוצר
לא ידוע
קישור
אירלנד
מרקים
חשש להימצאות חלקי פלסטיק קשיח במוצרים
לא ידוע
קישור
ניו זילנד
משקאות קלים
המוצר עלול להכיל חלקי זכוכית קטנים
לא ידוע
קישור
צרפת
אוכמניות ארוזות
סלמונלה
לא ידוע
קישור
ארה"ב
פילה סלמון
לא ידוע
מקור הדג ממדינת צ'ילה
קישור
ארה"ב
משקה סיידר תפוחים
סכנת מהתפוצצות בקבוקי הזכוכית
לא ידוע
על פי החברה, תהליך התסיסה של הסיידר נמשך ומעלה את הלחץ בתוך הבקבוקים.
קישור
קנדה
כנפי עוף
חשש לרעלני סטפילוקוקוס אאוראוס
לא ידוע
הכנפיים מוכנות לאכילה
קישור
קנדה
מגוון חברות
צדפות
כן - ידוע על מספר בני אדם אשר חלו
קישור
צרפת
סרדינים בשמן חמניות
חשד לנוכחות היסטמין
לא ידוע
קישור
ארה"ב
אבקת כוסברה
סלמונלה
לא ידוע
קישור
קנדה
משקאות אלכוהוליים
שברי זכוכית
לא ידוע
קישור
ארה"ב
פרוסות גבינה
סכנת חנק מחבק פלסטיק
לא ידוע על נפגעים אך התקבלו תלונות מצרכנים
החברה קיבלה 2 תלונות מצרכנים אשר נחנקו מהחבק
קישור
אנגליה
סלק מוחמץ
חשש לבוטולינום טוקסין
לא ידוע
תקלה העיבוד
קישור
דנמרק
קמח חיטה אורגני מתוצרת איטליה
חיפושיות וזחלים
לא ידוע
קישור
קנדה
בקבוקי בירה
סכנת התפוצצות בקבוקי הזכוכית
לא ידוע
קישור
ארה"ב
סלמונלה
לא ידוע
סלמונלה עשויה לגרום לתחלואה גם בכלבים ולהעברת המחלה גם לבני אדם כתוצאה מטיפול במזון.
קישור
ארה"ב
Western Milling
מזון לסוסים
monensin
ידוע על מוות של מספר סוסים אשר הוזנו באצווה הרלוונטית
קישור
צרפת
פטריות שחורות מיובשות
בצילוס צראוס
לא ידוע
קישור
ארה"ב - הוכרז גזר הדין בפרשת הסלמונלה בבוטנים משנת 2009
 בתום משפט ממושך אשר החל בשנת 2009, הוכרז גזר הדין התקדימי, אשר כולל 28 שנות מאסר בפועל למנהל המפעל ועונשי מאסר ממושכים לעוד מספר בעלי תפקידים בחברה.
בתום משפט ממושך אשר החל בשנת 2009, הוכרז גזר הדין התקדימי, אשר כולל 28 שנות מאסר בפועל למנהל המפעל ועונשי מאסר ממושכים לעוד מספר בעלי תפקידים בחברה.
ארה"ב וקנדה - התפרצות סלמונלה ממוצרי עוף קפואים
.jpg) שתי חברות אמריקאיות המייצרות מוצרי עוף קפואים נקשרו לשתי התפרצויות של סלמונלה. החברות הן Barber Foods ו Aspen Foods. בשני המקרים מדובר במוצרים שאינם מוכנים לאכילה, אך המראה שלהם עלול להטעות וליצור רושם כאילו שהם כן מוכנים לאכילה.
שתי חברות אמריקאיות המייצרות מוצרי עוף קפואים נקשרו לשתי התפרצויות של סלמונלה. החברות הן Barber Foods ו Aspen Foods. בשני המקרים מדובר במוצרים שאינם מוכנים לאכילה, אך המראה שלהם עלול להטעות וליצור רושם כאילו שהם כן מוכנים לאכילה.
לפי המרכז לבקרת מחלות בארה"ב אין קשר בין שני המקרים. הינשוף לא יכול שלא לשאול, האומנם? נמשיך לעקוב...
ארה"ב - מחקר מראה כי חיידקי Klebsiella עשויים לגרום למחלה במעבר דרך מזון
ממצאי המחקר מראים כי החיידק Klebsiella Pneumonia, אשר מצוי באופן טבעי בגופם של חלק מבני האדם וידוע כי עשוי להגיע מהסביבה, נמצא בכ-47% ממוצרי הבשר אשר נרכשו ממגוון רשתות גדולות ועשוי להגיע לאדם ולגרום לתחלואה במסלול זה.
ממצאי המחקר מראים כי החיידק Klebsiella Pneumonia, אשר מצוי באופן טבעי בגופם של חלק מבני האדם וידוע כי עשוי להגיע מהסביבה, נמצא בכ-47% ממוצרי הבשר אשר נרכשו ממגוון רשתות גדולות ועשוי להגיע לאדם ולגרום לתחלואה במסלול זה.
בולגריה - ארבעה בני אדם נעצרו בחשד למכירת בשר נגוע באנטרקס
 החשד הינו כי הבשר הנגוע נטחן והוכנס למוצרי קציצות ונקניקיות שונים. בנוסף קיים חשש מזיהום צולב של מוצרים נוספים בבתי העסק אליהם הגיע הבשר הנגוע.
החשד הינו כי הבשר הנגוע נטחן והוכנס למוצרי קציצות ונקניקיות שונים. בנוסף קיים חשש מזיהום צולב של מוצרים נוספים בבתי העסק אליהם הגיע הבשר הנגוע.
סימני המחלה כוללים כאבי בטן, אובדן תיאבון, שלשולים וחום. המחלה ניתנת לטיפול אנטיביוטי ובכ-50% מהמקרים בהם החולה לא מקבל טיפול היא עלולה לגרום למוות.

.jpg)